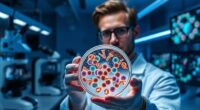

Heat waves don’t just affect your body; they pose real risks to your mental health too. Rising temperatures can disturb your sleep, making it harder to relax and process emotions. The discomfort and frustration from the heat can increase anxiety, irritability, and feelings of helplessness. Social isolation may worsen during hot weather, leading to loneliness and depression. Pay attention to how extreme heat impacts your mood—you’ll find ways to protect your well-being as you explore further.
Key Takeaways
- Heat waves disrupt sleep, impairing emotional regulation and increasing irritability, anxiety, and depression.
- Elevated temperatures heighten stress and feelings of helplessness, especially in vulnerable populations.
- Sleep deprivation from heat hampers emotional processing, leading to emotional instability and social withdrawal.
- Limited outdoor activity and social interaction during heat waves exacerbate loneliness and mental health issues.
- Urban heat amplifies mental health challenges, requiring proactive strategies to create calming environments and support resilience.

As heat waves become more frequent and intense, their impact extends beyond physical health, considerably affecting mental well-being. One of the most immediate and noticeable effects is how urban heat exacerbates the problem. Cities tend to trap heat due to concrete, asphalt, and limited green spaces, creating an urban heat island effect. This relentless rise in temperature doesn’t just make daytime activities uncomfortable; it also disrupts your sleep patterns. When the nights are hot and humid, it becomes much harder to fall asleep or stay asleep through the night. Sleep disruption isn’t just about feeling tired; it can deeply influence your mood, cognitive function, and emotional resilience. Without restful sleep, you’re more prone to irritability, anxiety, and even depression, making it harder to cope with the stressors that heat waves bring. In addition, high temperatures can impair the body’s ability to regulate stress hormones, further impacting mental health.
Urban heat worsens sleep issues, impacting mood, cognition, and emotional resilience during heat waves.
The mental toll of persistent heat isn’t limited to just feeling groggy or cranky. When your body struggles to cool down, your brain is affected too. Elevated temperatures can lead to increased feelings of frustration and helplessness, especially if you live in an area where cooling options are limited or expensive. The constant discomfort can amplify existing mental health issues or trigger new ones, creating a cycle where heat worsens emotional well-being. Sleep deprivation caused by urban heat makes it difficult to process emotions properly, leading to heightened anxiety and difficulty concentrating. Over time, this can erode your resilience, making everyday challenges seem even more overwhelming.
Moreover, heat waves can induce a state of heightened stress, which further wears down mental health. The worry about how to stay safe, find relief, or pay for increased cooling costs adds an extra layer of anxiety. If you’re already vulnerable—such as elderly individuals or those with pre-existing mental health conditions—the effects can be even more severe. Sleep disturbances caused by urban heat can lead to a vicious cycle: poor sleep heightens stress levels, which in turn makes it even harder to sleep, escalating feelings of despair or agitation. The constant heat also limits outdoor activities and social interactions, which are essential for emotional health. Isolation during heat waves can deepen feelings of loneliness, depression, and anxiety, especially when you’re unable to escape the oppressive environment.
In short, the mental health effects of heat waves are profound and multi-layered. As urban heat intensifies, so does the disruption to sleep and emotional stability. Addressing these issues requires more than just cooling strategies; it demands awareness of how heat impacts mental well-being and proactive measures to mitigate its effects on your mind, not just your body. Recognizing the importance of color accuracy in visual environments can also help create more calming and mentally soothing spaces during extreme heat.

DREO Tower Fan for Bedroom, 2026 Upgraded DC Motor, 28ft/s High Velocity, 20dB Ultra Quiet Standing Fan, 8 Speeds 4 Modes, 90° Oscillating Bladeless Fan for Indoors, Floor Fans with Remote, Black
𝐌𝐨𝐫𝐞 𝐏𝐨𝐰𝐞𝐫𝐟𝐮𝐥 𝐰𝐢𝐭𝐡 𝐮𝐩𝐠𝐫𝐚𝐝𝐞𝐝 𝐃𝐂 𝐦𝐨𝐭𝐨𝐫: Thanks to DREO's upgraded brushless DC motor combined with TurboWind technology, the…
As an affiliate, we earn on qualifying purchases.
As an affiliate, we earn on qualifying purchases.
Frequently Asked Questions
Can Heat Waves Trigger Mental Health Disorders?
Heat waves can indeed trigger mental health disorders, especially if you’re sensitive to urban stress and sleep disruption. When temperatures soar, you might feel increased anxiety, irritability, or depression. Sleep becomes harder to get, compounding these effects. The urban environment amplifies stress, making it essential to find ways to stay cool and maintain healthy sleep routines. Ignoring these signs can worsen your mental health over time.
How Quickly Can Heat Waves Impact Mental Well-Being?
Ever wonder how quickly heat waves can impact your mental well-being? Urban heat and sleep disruption hit fast, sometimes within days. You might feel irritable or anxious as your environment becomes uncomfortably hot, disrupting your sleep and increasing stress. The constant exposure to high temperatures can heighten feelings of helplessness or depression. So, yes, heat waves can swiftly influence your mental health, often before you even realize it’s happening.
Are Children More Vulnerable to Heat-Related Mental Health Issues?
You might wonder if children are more vulnerable to heat-related mental health issues. Child vulnerability is higher because their developing brains and limited coping skills make them more sensitive to extreme temperatures. Heat waves can disrupt pediatric mental health by increasing anxiety, agitation, and stress. As a result, you should pay extra attention to a child’s behavior during heat waves, ensuring they stay cool, hydrated, and emotionally supported to protect their mental well-being.
What Coping Strategies Help During Extreme Heat?
During extreme heat, you can protect yourself by using indoor cooling methods like air conditioning or fans to stay comfortable. Stay hydrated by drinking plenty of water and avoiding caffeine or alcohol, which can dehydrate you. Wearing lightweight, breathable clothing and limiting outdoor activities during the hottest parts of the day also help. These strategies keep your body cool and reduce stress, supporting your mental well-being during heat waves.
Do Heat Waves Increase Rates of Self-Harm or Suicide?
Imagine a storm inside your mind—heat waves can do that. Rising temperatures increase urban stress and cause sleep disruption, which heightens the risk of self-harm and suicide. As the heat persists, your mental resilience weakens, making you more vulnerable. It’s essential to recognize these signs and seek support. Heat isn’t just a physical challenge; it can stir emotional turmoil, amplifying mental health struggles during extreme weather events.

Cooling Pad Mat for Pillow – Cold Injuries Relief, Perfect for Night Sweats, Migraines, Fevers, Hot Flashes – Reusable (Blue)
The right size: Each product has been carefully designed and modified several times, so that the size of…
As an affiliate, we earn on qualifying purchases.
As an affiliate, we earn on qualifying purchases.
Conclusion
As you experience more frequent heat waves, remember that over 60% of people report feeling more anxious and irritable during extreme heat. It’s not just your body that suffers; your mental health takes a hit too. Staying cool, hydrated, and connected can help you cope. Recognizing these impacts means you can take action to protect your mind, just as you do your body. Staying mindful now can make all the difference in weathering future heat waves.

EF ECOFLOW WAVE 3 Portable Air Conditioner with Battery and Drain Pipe, 1800W/6100 BTU Cooling and 2000W/6800 BTU Heating, 1000W Fast Charging in 75 mins, 8H Wireless Running, APP Control
HyperSpeed Climate Control: 1800W cooling (20% more BTU than competitors) drops 15°F in 15mins under extreme heat. 2000W…
As an affiliate, we earn on qualifying purchases.
As an affiliate, we earn on qualifying purchases.

Transcend AirMist
Sleep Transformation: Reclaiming Your Rest
As an affiliate, we earn on qualifying purchases.
As an affiliate, we earn on qualifying purchases.